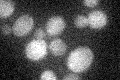
YJL050W
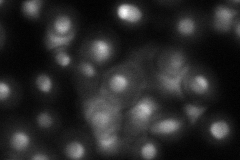
YJL050W

View description
ATP-dependent 3'-5' RNA helicase, involved in nuclear RNA processing and degredation both as a component of the TRAMP complex and in TRAMP independent processes; member of the Dead-box family of helicases
Localization:
Intensity:
Fold change:
Significance:
-
C’ GFP library in SD
below threshold16.91 -
N' NOP1pr-GFP in SD

nucleus159.069 -
N' TEF2pr-mCherry in SD

nucleus190.288 -
N' NATIVEpr-GFP in SD
nucleus,nucleolus76.3541 -
N' TEF2pr-VC and Cyto-VN in SD

nucleus62.5949 -
C’ GFP library in SD+DTT

cytosol15.290.9No -
C’ GFP library in SD+H2O2

cytosol17.811.05No -
C’ GFP library in Starvation Media

cytosol16.140.95No -
C’ GFP library on the background of Pup2-DaMP

below threshold -
C’ GFP library on the background of CCT mutant

below threshold19.06251.1268No
